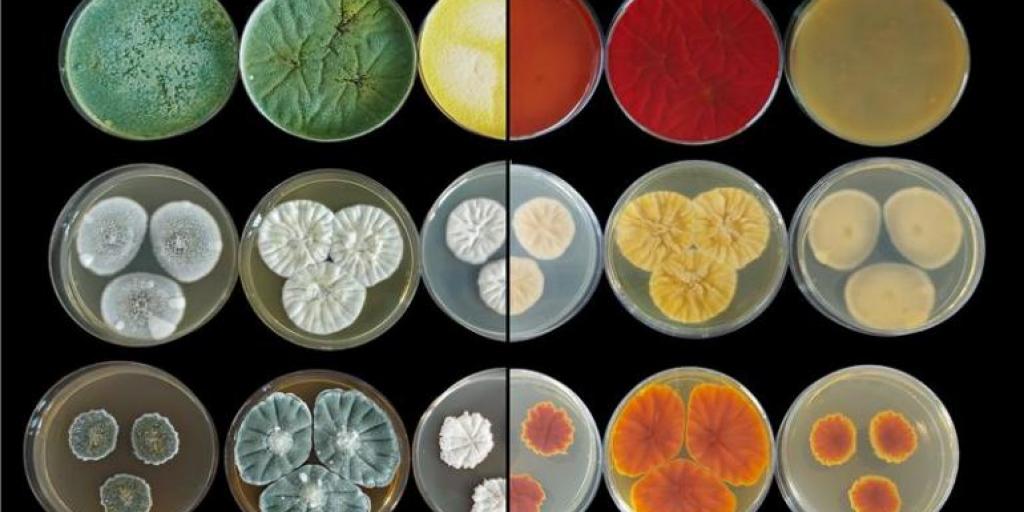
foto di una collezione di organismi da laboratorio

"La conservazione dei funghi e dei microrganismi non significa solo tradizione gastronomica, ma anche salute, ambiente e nuove prospettive biotecnologiche".
Quando si affronta il tema della conservazione dei funghi, l'attenzione comune è quasi sempre circoscritta alle metodologie per preservare gli sporomi (o corpi fruttiferi) commestibili. Tuttavia, la micologia richiede un approccio di conservazione ben più ampio e diversificato. La conservazione scientifica si concentra sull'istituzione di ceppoteche e banche genetiche che mantengano la vitalità e l'integrità dell’organismo fungino, garantendone la disponibilità per studi futuri negli ambiti più disparati.
La strategia di conservazione non si limita al mero mantenimento della vitalità degli organismi, ma si estende alla loro identificazione tassonomica e alla caratterizzazione dei tratti funzionali e delle proprietà metaboliche specifiche.
Grazie al finanziamento ottenuto tramite il progetto SUS-MIRRI.IT, nell'ambito del PNRR, l’Università di Genova ha compiuto un passo decisivo nell’implementazione scientifica e tecnologica della sua storica micobanca ColD-UniGe, la Collection of DISTAV.
ColD-UniGe rappresenta un centro di riferimento per la conservazione di microrganismi e comprende un'ampia varietà di organismi: funghi filamentosi isolati nel Laboratorio di micologia, lieviti provenienti dal Laboratorio di biologia molecolare e biotecnologie marine e batteri isolati nel Laboratorio di microbiologia, genetica ed evoluzione microbica.
Unica nel suo genere nella Regione Liguria, la collezione costituisce una risorsa strategica per la conservazione della biodiversità microbica e per lo sviluppo di attività di ricerca di base e applicata, a livello locale, nazionale e internazionale.
Per approfondire l'argomento potete visitare il nostro magazine d'ateneo: unige.life.it